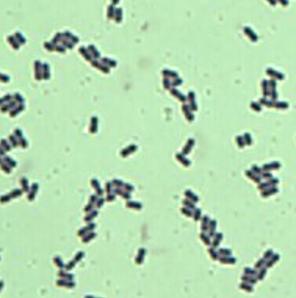

トップページ > しごと・産業 > 農林水産業 > 農業 > 農業総合研究センター > 農業総合研究センター > 奈良新聞掲載記事集 > 乳酸菌のはなし
印刷
ページ番号:18157
更新日:2026年4月14日
ここから本文です。
乳酸菌のはなし
乳酸菌とはブドウ糖や乳糖などの糖をエネルギー源として利用し、乳酸を多く作りだす細菌の総称です。近年新しい乳酸菌が次々と発見され、色々な食品・飲料で応用されていますが、実は昔から私たちの食生活と深いつながりがありました。例えばお漬物。皆さん、ぬか漬けを長く放置していると酸っぱくなった経験はありませんか。これは腐敗しているわけではなく、ぬか床や野菜にいる乳酸菌による乳酸発酵で乳酸ができたためです。乳酸は食酢とはまた異なるまろやかな味の酸ですが、その酸性により、腐敗を招く菌の繁殖を抑え、生では傷みやすい食材の長期保存を可能にしてきました。スンキ、鮒ずし、クサヤ、味噌なども、この働きを利用した食品です。更に、これら食品は何ともやみつきになる独特の味をしています。これはタンパク質が分解されてできるグルタミン酸などのアミノ酸や、コハク酸などの有機酸によるもので、この分解にも乳酸菌は一役買っています。
さて、私たちはこのような食品を介して、知らず知らずのうちに乳酸菌を摂取してきたわけですが、乳酸菌は、体内に入ってからも、作り出す乳酸により悪い菌の増殖を抑え、腸内環境を整えるなど、重要な働きをしています。他にも血圧を下げる効果や、腸内の免疫細胞の活性化など、近年様々な働きが報告されています。
乳酸菌に代表されるように、腸内において有益な働きをする微生物、またはそれを含む食品は「プロバイオティクス」と呼ばれます。もう一つ、よく似た「プレバイオティクス」という言葉も最近耳にされるでしょう。これは、腸に届いてプロバイオティクスの栄養源となる食品成分で、食物繊維やオリゴ糖が該当します。オリゴ糖は、大豆、はちみつ、玉ねぎのほか、バナナなどに多く含まれます。日々の健康のために乳酸発酵食品を採るのはもちろん、乳酸菌を存分に活躍させるためにも、こちらも同時に取り入れたいものですね。
豆知識
日本に昔から伝わるお茶に、徳島の阿波番茶や、高知の碁石茶といった発酵茶があります。これらは緑茶の葉を乳酸菌やその他の微生物の力で発酵させたお茶で、淡い酸味やまろやかな風味が特徴です。奈良県農業研究開発センターでは、このような発酵茶を、特産の柿に由来する柿の葉でできないかと研究に取り組んでいます。柿の葉寿司でご存じのとおり、柿の葉には抗菌作用があることから、これに負けない乳酸菌を、まず探さなければなりません。そこで、県内の桜の花や葉、柿の葉から乳酸菌を探し出し、柿葉でも発酵が可能な菌を選抜しました。そのうちの最も元気な菌で柿の葉茶を発酵させたところ、すっきりした酸味の、爽やかなお茶が得られました。現在商品化に向けて開発を進めており、近い将来、柿と並んで奈良の名物になることを期待しています。
(写真 左:柿葉茶の発酵に用いた乳酸菌(Lactiplantibacillus plantarum) 右:柿葉発酵茶)